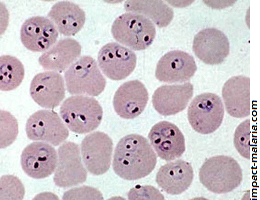
seminario bioevol

Eventos passados
Confira os próximos eventos Titulo: UV-Photophysiology in Marine Animals - Science meets Commercial Opportunity
Titulo: UV-Photophysiology in Marine Animals - Science meets Commercial Opportunity
Palestrante: Paul Long - King’s College London
Data: 04/04
Hora: 12h30 – 14h
Local: AG da Zoologia – IB/USP
Next week we have a great talk from another visiting scientist at our institute. Paul has been collaboration with Tim Marques in our Department on proteomic studies and evolution of toxins of cnidarians. Don’t miss out his talk! He has sent the attached paper to further enlighten the discussion after his talk on Friday.
Leia mais
 Titulo:Functional Approach in Vertebrate Evolution
Titulo:Functional Approach in Vertebrate Evolution
Palestrante:Anick Abourachid – Museu Nacional de História Natural - França
Data: 28/03
Hora: 12h
Local:Auditório Geral da Zoologia
Titulo: Dimorfismo alélico em antígenos do parasita da malária Plasmodium falciparum: origem e implicações para o desenvolvimento de vacinas
Titulo: Dimorfismo alélico em antígenos do parasita da malária Plasmodium falciparum: origem e implicações para o desenvolvimento de vacinas
Palestrante: Marcelo Urbano Ferreira – ICB/USP
Data: 28/03
Hora: 14h
Local: Sala 2 – Edifício Minas Gerais
Leia mais
![]() Titulo: I Encontro da Pós-Graduação da USP
Titulo: I Encontro da Pós-Graduação da USP
Data: 28/03
Hora: 18h
Local: FEA-II, prédio em amarelo
 Titulo: Globalização
Titulo: Globalização
Palestrante: Tony Chan Reitor da The Hong Kong University of Science and Technology (HKUST)
Data: 02.04.2014
Hora: 15:30h-16:30h
Local: Instituto de Matemática e Estatística (IME) - Auditório Antonio Gilioli R. do Matão, 1010 - Bloco A - Cidade Universitária - São Paulo

